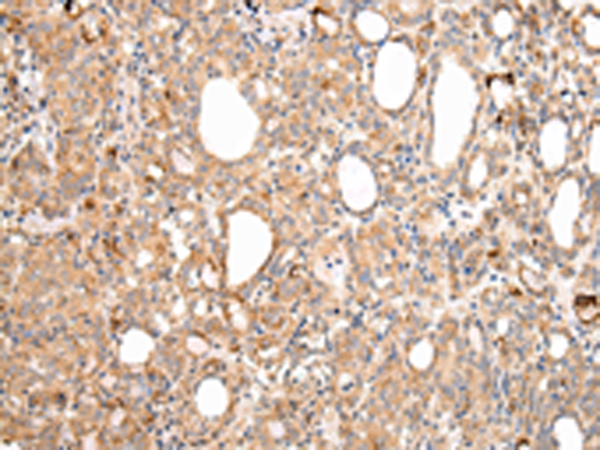

中文名稱: 兔抗AXIN1 多克隆抗體
|
Background: |
This gene encodes a cytoplasmic protein which contains a regulation of G-protein signaling (RGS) domain and a dishevelled and axin (DIX) domain. The encoded protein interacts with adenomatosis polyposis coli, catenin beta-1, glycogen synthase kinase 3 beta, protein phosphate 2, and itself. This protein functions as a negative regulator of the wingless-type MMTV integration site family, member 1 (WNT) signaling pathway and can induce apoptosis. The crystal structure of a portion of this protein, alone and in a complex with other proteins, has been resolved. Mutations in this gene have been associated with hepatocellular carcinoma, hepatoblastomas, ovarian endometriod adenocarcinomas, and medullablastomas. Two transcript variants encoding distinct isoforms have been identified for this gene. |
|
Applications: |
ELISA, IHC |
|
Name of antibody: |
AXIN1 |
|
Immunogen: |
Synthetic peptide of human AXIN1 |
|
Full name: |
axin 1 |
|
Synonyms: |
AXIN; PPP1R49 |
|
SwissProt: |
O15169 |
|
ELISA Recommended dilution: |
2000-5000 |
|
IHC positive control: |
Human liver cancer and Human lung cancer |
|
IHC Recommend dilution: |
25-100 |
購(gòu)物車
幫助
021-54845833/15800441009
